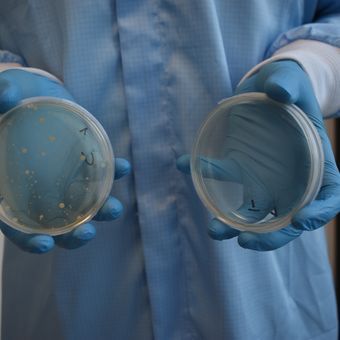

bacterial protection
Our garments safeguard your environment against microbial contamination while supporting effortless, compliant performance.
Contamination control
our reusable cleanroom garments
In environments where the smallest trace of contamination can have major consequences, every detail matters. Our garments are designed to provide maximum protection against particle and microbial contamination, without compromising on comfort or functionality.
the industries we supply for
ALSICLEAN® technology
ALSICLEAN fabrics are engineered for the most critical cleanrooms where microbial and particle control are mandatory. The micro-filament yarns and tightly woven structure create micropores small enough to block 99% of contaminants while maintaining breathability.
Validated for GMP Grade A/B cleanroom requirements and proven to withstand over 80 sterilization cycles, the material maintains its non-linting performance, delivers >99% particle filtration efficiency, and is fully compatible with all sterilization methods.



view our clean area brochure
ALSISKIN® technology
ALSISKIN represents the most comfortable fabric technology within our contamination control range, designed for use in clean areas and controlled environments. The texturized microfilament yarns and antistatic properties provide a soft, non-clinging feel, while the tight, no-lint structure minimizes particle dispersion. Its breathable, quick-dry design ensures lasting comfort without compromising the cleanroom integrity or durability of the garment.


cyclop®
an award-winning innovation
for cleanroom environments
In cleanrooms around the world, people work on innovations that improve our lives. However since Annex 1 requires that facial skin should be covered at all times, the working circumstances inside those cleanrooms have become even more challenging.
Don’t you agree these people deserve an innovation that improves their working lives?
Cyclop® is a cleanroom coverall with integrated panoramic goggles and a built-in ventilation circuit. It eliminates all skin exposure, provides fog-free vision, and delivers a continuous flow of fresh air to the wearer. GMP Annex 1 compliance and operator comfort is addressed in a single garment system.

BI-OME®
antimicrobial innovation
BI-OME® is designed to reduce bacterial contamination on cleanroom garments, helping limit microbial dispersion and measurable CFU levels in controlled environments. The technology provides durable antimicrobial performance without the use of metals or silver ions.
BI-OME® works through a physical mode of action: microorganisms are attracted to the surface, where their cell membranes are deactivated on contact. This ensures consistent microbial reduction, even after more than 100 industrial launderings. Certified according to OEKO-TEX Standard 100 (Class 1), BI-OME® supports both contamination control and wearer comfort.
frequently asked questions
Conventional clothing is not suitable for use in cleanroom environments, as standard textiles are not designed to control particle or microbial release. Natural fibers such as cotton or wool, as well as non–cleanroom-specific synthetic garments (e.g., leisurewear or fleece), are known to shed fibers and particles, presenting an unacceptable contamination risk.
In addition, personal items that may generate, retain, or transfer contamination such as scarves, jewelry, watches, cosmetics, or makeup are not permitted within controlled environments.
Only garments specifically designed for cleanroom use, made from low-linting, non-shedding materials and subjected to defined testing and validation, are permitted within controlled areas. Depending on the cleanroom classification (ISO or GMP Grade) and process type, operators wear a full protective system that includes a coverall, hood, mask, gloves, and overshoes.
These garments are constructed from low-linting, high-filtration fabrics that contain particles, fibers, and microorganisms within the suit. In aseptic environments, additional sterile layers may be required to ensure full process protection.
Cyclop is an innovative cleanroom garment featuring integrated goggles and a ventilation system, providing complete protection and comfort for the wearer.
Designed to meet strict GMP Annex 1 requirements, it prevents contamination by eliminating skin exposure while keeping operators cool and focused through continuous airflow.
GMP Annex 1 is a key European guideline that sets the standards for the manufacture of sterile products. It defines how cleanrooms should be designed, operated, and maintained, including strict requirements for clothing, behavior, and contamination control.
To remain compliant, operators must wear validated cleanroom garments that prevent both microbial and particle contamination.
Yes, alsico offers customization options for a wide range of cleanroom garments, including uniforms, lab coats, coveralls, and hoods. Customization can include sizing, fit, fabric selection, colors, and additional features to meet specific cleanroom requirements or company standards. This enables organizations to maintain both contamination control and staff comfort, while aligning with operational needs and regulatory compliance.
get in touch
contact form
latest contamination control stories
)








